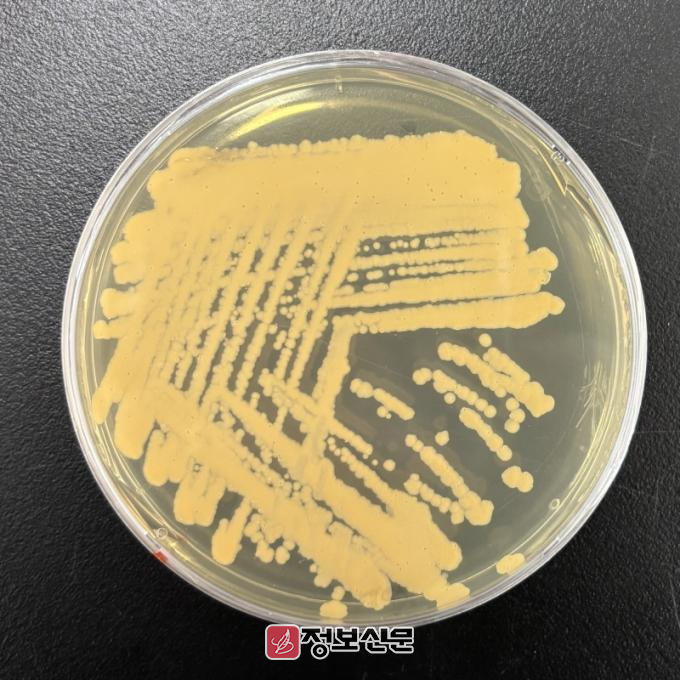

![]() 국립호남권생물자원관, 녹조 독소 분해 세균 발견 |
이번에 발견된 세균 ‘로도코커스 큉솅지(학명: Rhodococcus qingshengii)’는 남조류에서 분비되는 독소인 마이크로시스틴을 분해하는 특징을 갖고 있다. 마이크로시스틴은 특정 남조류가 분비하는 대표적 독소로, 인체 발암성 물질로 알려져 있다.
이 독소는 식수원으로 사용되는 강, 호수, 저수지 등 다양한 수역에서 검출되며, 해외에서는 동물 집단 폐사의 원인으로도 보고되고 있다.
연구진은 이 균주를 활용한 실험을 통해, 해당 세균의 독소 분해 능력은 일일 486.8μg/L이며, 이는 표준균주 대비 20배 이상 높은 분해 능력에 해당하는 것을 밝혀냈다. 또한, 이 세균이 생태계 내 다양한 미생물 및 수생 생물의 성장을 저해하지 않고도 독성 물질을 제거할 수 있어, 2차 오염이나 생태계 교란을 최소화하는 친환경적 해결책을 제시할 수 있을 것이라 기대하고 있다.
국립호남권생물자원관은 2024년부터 '도서·연안 야생 생물자원 활용 유해 생물 방제 기술 개발' 연구사업 추진을 통해 해당 세균을 발굴하였으며, 관련 기술에 대한 특허를 출원했다.
최경민 도서생물융합연구실장은 “기후변화로 인해 유해 남조류 독소 문제가 심화되는 가운데, 이번 연구성과는 생물자원 기술을 통해 국민 건강 증진에 기여할 수 있는 방안을 제시한다는 점에서 의미가 크다”라며 “앞으로도 안정적이고 지속 가능한 생물자원 활용 기술 개발을 위해 최선을 다하겠다”라고 밝혔다.
김금덕 기자 jbnews24@naver.com
2026.02.08 (일) 15:39